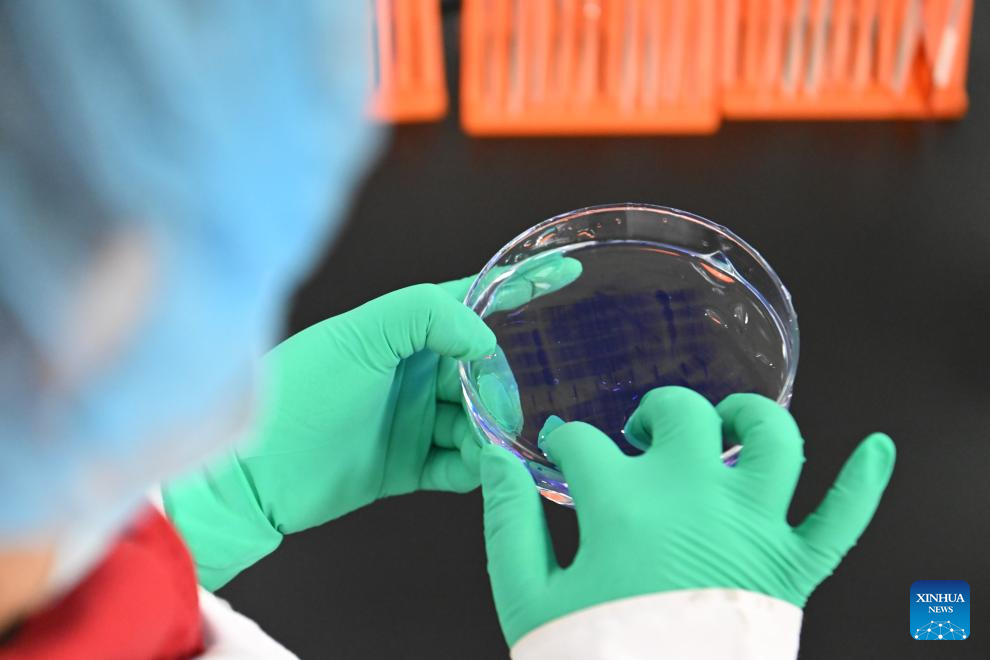

| spanish.china.org.cn | 25. 02. 2025 |
Editor:Filo Fu
|
 |
 |
 |
 |
 |
[A A A] |
La Ciudad Tecnológica Zhongguancun de Beijing-Tianjin registra diversos actores del mercado
Palabras clave:
China, Tecnología
Spanish.china.org.cn |
25. 02.
2025
Un miembro del personal comprueba el estado de una placa de Petri en una empresa biomédica de la Ciudad Tecnológica Zhongguancun de Beijing-Tianjin, en Tianjin, norte de China, el 20 de febrero de 2025.
-
La Ciudad Tecnológica Zhongguancun de Beijing-Tianjin registra diversos actores del mercado
-